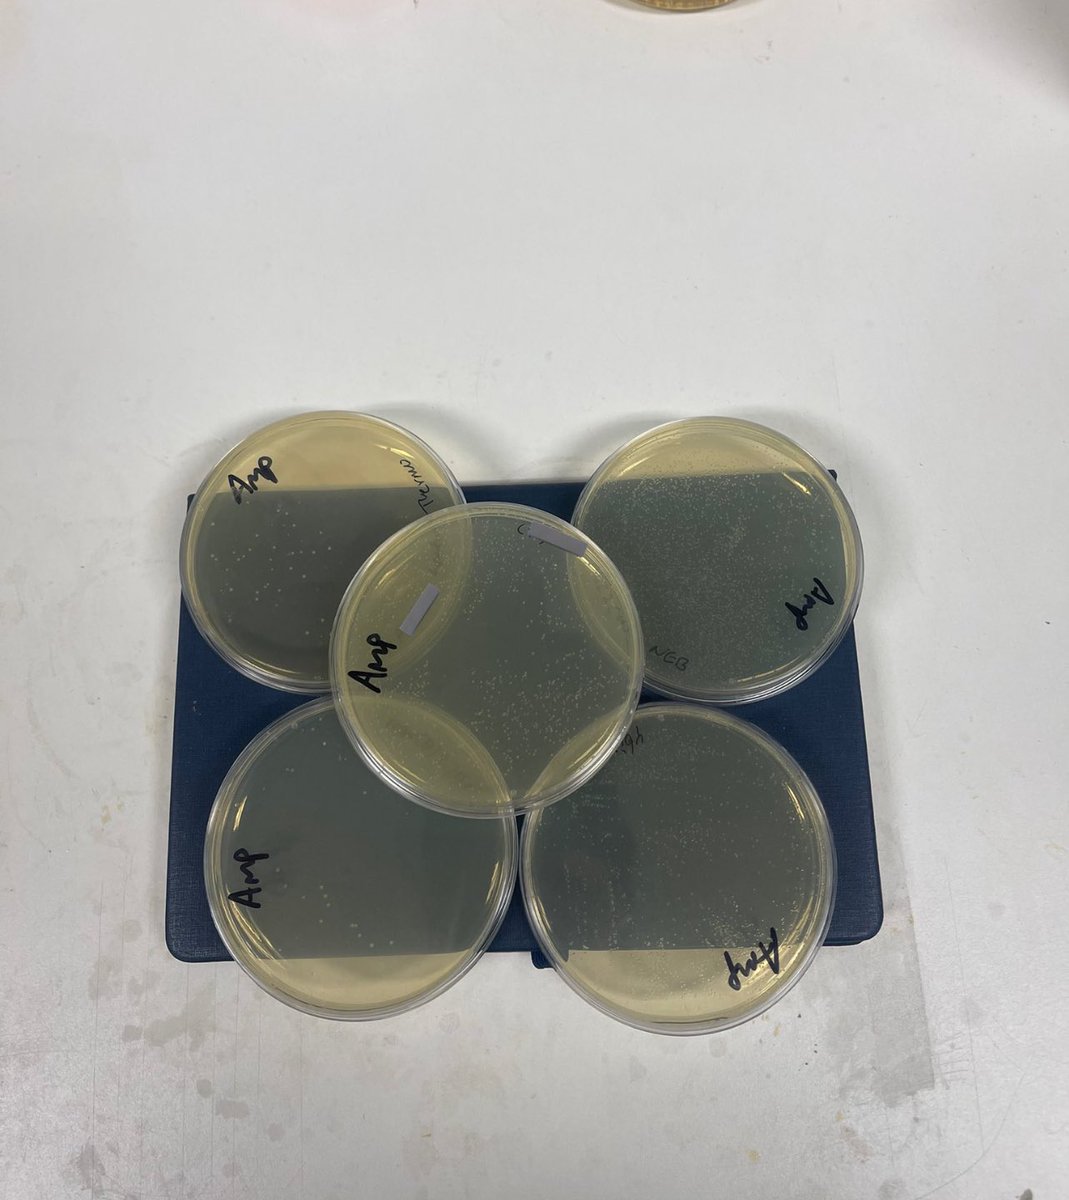

Faisal
@f__mals
Saudi
ID: 223090933
05-12-2010 10:53:36
13,13K Tweet
15,15K Followers
913 Following
















الفكرة بدءت عبر Hosam Zowawi بتوصيتي كباحث مهتم بالبروتينات، ثم تواصلت معي رؤيا بكل حماس واصرار و نشرنا ملصق علمي في اكبر مركز بحثي للأحياء البنيوية. بعد ذلك توصية من Abeer Alharbi و تدريب معملي من Dr. Safia Salim كان له الدور في تجهيز رؤيا لخوض غمار تجربة وتدريب صيفي في جامعة أوكسفورد.